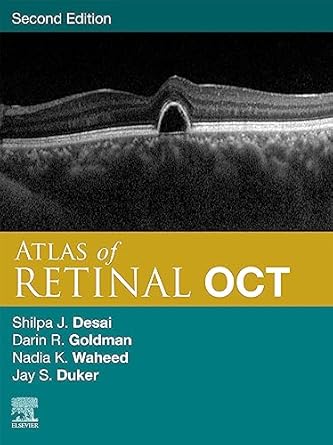

Atlas of Retinal OCT E-Book: Optical Coherence Tomography
Kindle Edition or EPUB + Converted PDF نویسندگان: Jay S. Duker, Nadia K. Waheed, Darin Goldman
جزئیات
فرمت: Kindle Edition or EPUB + Converted PDF ناشر: Elsevier; 2nd edition (June 6, 2023) تاریخ انتشار نسخه الکترونیکی : June 6, 2023
؟
شابک: 9780323930437 لینک: https://www.amazon.com/dp/B0C7H63ZSD
1,449,000 تومان
زمان تحویل: حداکثر 24 ساعت
توضیحات
Unparalleled for aiding diagnosis of retinal disease and recording disease progression, Optical Coherence Tomography (OCT) remains one of the most significant advances in ophthalmology over the past 50 years. Atlas of Retinal OCT, 2nd Edition, provides expert guidance in making the most of this diagnostic tool with high-quality, oversized images that show precise detail and assist with rapid, accurate clinical decision making. Led by the same expert team of Drs. Jay S. Duker, Nadia K. Waheed, and Darin R. Goldman, and with the addition of new editor Dr. Shilpa J. Desai, this atlas remains your “go to reference source for OCT imaging of the retina. Now updated throughout to align with current practice, it covers a range of both common and rare disorders and presentations.Features more than 1,000 high-quality illustrations depicting the full spectrum of retinal diseases using OCT and OCTA scans, supported by clinical photos and ancillary imaging technologies.Contains new and updated image examples throughout—including new OCTA images with artifacts and key findings highlighted.Presents images as large as possible on the page with an abundance of arrows, pointers, and labels to guide you in pattern recognition and eliminate any uncertainty.Includes the latest high-resolution spectral domain OCT technology and new insights into OCT angiography technology to ensure you have the most up-to-date and highest quality examples available.Provides key feature points for each disorder, giving you the need-to-know OCT essentials for quick comprehension and rapid reference.An excellent diagnostic companion to Handbook of Retinal OCT: Optical Coherence Tomography, 2nd Edition.An eBook version is included with purchase. The eBook allows you to access all of the text, figures and references, with the ability to search, customize your content, make notes and highlights, and have content read aloud.
1,449,000 تومان
زمان تحویل: حداکثر 24 ساعت



